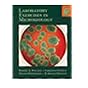

Molecular Design of Life / Lubert Stryer.
Material type: TextPublication details: New York : W.H. Freeman and Co., c1989.Description: xiv, 215 p. : ill. (some col.) ; 28 cmISBN:
TextPublication details: New York : W.H. Freeman and Co., c1989.Description: xiv, 215 p. : ill. (some col.) ; 28 cmISBN: - 0716720507 (pbk.)
- 0716720493 (hard)
- 574.88 19 STR
| Item type | Current library | Call number | Status | Barcode | |
|---|---|---|---|---|---|
 Open Shelf Books
Open Shelf Books
|
Hamu Mukasa Library Open Access / General collection; Level 2 | 574.88 STR (Browse shelf(Opens below)) | Available | 87357 |
Browsing Hamu Mukasa Library shelves,Shelving location: Open Access / General collection; Level 2 Close shelf browser (Hides shelf browser)

|

|
No cover image available No cover image available |

|

|

|
|
||
| 574.52632 HOR Limnology / | 574.52632 HOR Limnology / | 574.52652 LEO The Desert / | 574.88 STR Molecular Design of Life / | 575 ATT Life on Earth : | 575 JON Darwin on Trial / | 575 LAB Laboratory Exercises in Microbiology / |
Eight chapters from the 3rd ed. of Stryer's Biochemistry, published in 1988.
Includes bibliographies and index.
There are no comments on this title.
Log in to your account to post a comment.
